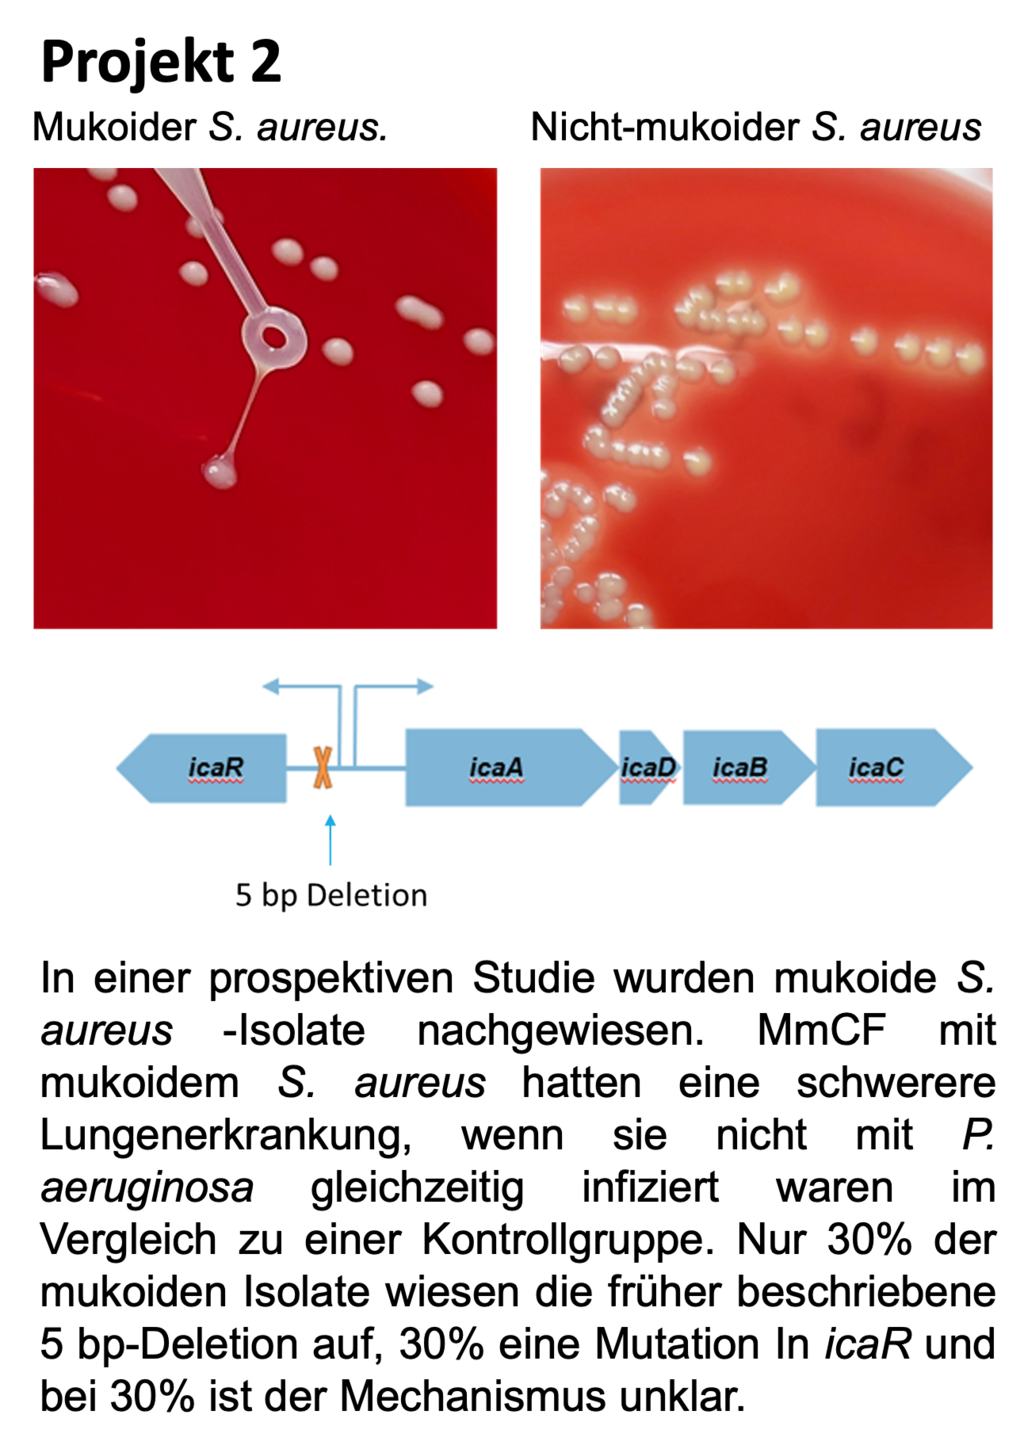

Mukoviszidose, auch als Cystische Fibrose (CF) bezeichnet, ist eine der häufigsten tödlich verlaufenen angeborenen seltenen Erkrankungen.
Ursache der Erkrankung ist eine Mutation des sogenannten CFTR-Gens (Cystisches Fibrose-Transmembran-Regulator-Gen) auf dem Chromosom 7. Es werden mehrere Mutationen unterschieden, die häufigste heißt F508del. Das CFTR-Gen ist verantwortlich für die Herstellung eines Ionenkanals, der den Salz- und Wasserhaushalt auf den Schleimhäuten der Lunge und anderer Organe reguliert. Durch den Gendefekt kann jedoch nur ungenügend oder überhaupt kein Chlorid und damit keine Flüssigkeit aus den Zellen auf die Atemwegsoberfläche transportiert werden.
Damit trocknen bei Mukoviszidose-Betroffenen die Schleimhäute der Atemwege aus. Es bildet sich so ein zähflüssiger Schleim, der unter anderem die Atemwege verstopft und einen hervorragenden Nährboden für Keime bietet. Krankheitserreger wie Bakterien können eine chronische Entzündung der Atemwege verursachen und dadurch das Lungengewebe zerstören. Das Ausmaß der Beeinträchtigung der Lunge ist somit der kritische Faktor, der die Lebenserwartung und -qualität bestimmt. Mukoviszidose wird autosomal-rezessiv vererbt – also eine Person erkrankt nur, wenn sie von beiden Elternteilen eine mutierte Genvariante erbt. Ungefähr jeder 20. Mensch trägt ein verändertes (mutiertes) CFTR-Gen in seinem Erbgut.

Zwei Projekte sollen in Kürze weiterbearbeitet werden:
Die Kosten von 45.000 Euro wurden von der Deutschen Förderungsgesellschaft zur Mukoviszidoseforschung e.V. übernommen.
Aus eine prospektiven Studie mit 14 Individuen mit Mukoviszidose (PmCF) stehen aus 58 Ambulanzbesuchen aus den Sputen der PmCF mehr als 2000 S. aureus Isolate zur Verfügung. Aus jedem Sputum wurden 40 Isolate kultiviert und bereits sehr gut charakterisiert, siehe Wieneke et al, 2021. Die Resistenztestung ergibt sehr interessante Verläufe, die individuell sind. Für die abschließenden Untersuchungen der Resistenzdynamik müssen noch weitere 200 Isolate mit der Ganzgenomsequenzierung untersucht werden.
Kosten für die Ganzgenomsequenzierung: 25.000€

In den letzten Jahren haben wir uns den mukoiden S. aureus Isolaten gewidmet, die wir als erste 2016 beschrieben haben. Im Unterschied zu den mukoiden Isolaten von Pseudomonas aeruginosa, die sehr leicht zu erkennen sind, sind diese S. aureus Typen nur schwer erkennbar und bedürfen viel Erfahrung und den Einsatz von Spezialagar.
Wir haben gerade eine Studie zum Häufigkeit der mukoiden S. aureus Isolate bei PmCF abgeschlossen (multizentrisch und prospektiv, in die wir 628 PmCF aus 12 Zentren in Deutschland und 1 Zentrum in Österreich eingeschlossen haben). Das Manuskript ist bei einer internationalen Zeitschrift eingereicht und wir hoffen, dass die Studie dann bald veröffentlicht wird.
Für viele der mukoiden Isolate konnten wir noch keinen Mechanismus nachweisen, sodass es spannend wird, herauszufinden, was der Mukoidität dieser Isolate zugrunde liegt.
Kosten für diese Untersuchung von ca. 150 S. aureus Isolaten, inklusive Ganzgenomsequenzierung: 20.000€
Für den Muko-Patienten Reiner Heske sind Marathonläufe kein Problem

Auch Reiner Heske (Foto) aus Wiehl (Oberbergischer Kreis) streifte sich 2018 erstmalig das Trikot der Muko-Bike-Tour über. Für ihn ist die rund 90 Kilometer lange Strecke heutzutage kein Problem mehr – vor wenigen Jahren hatte das noch ganz anders ausgesehen. Um den Mukoviszidose-Patienten stand es 2013 nicht gut, und nur eine Spenderlunge konnte sein Leben retten. „Schon mit 15 war meine Lunge schwer“, so Reiner Heske, der Marathons läuft und beim ehemaligen legendären Radrennen „Rund um Köln“ und anderen mitfährt. „Dass ich aber überhaupt 40 Jahre alt wurde, war schon ein echtes Wunder. Als die Ärzte bei mir im Alter von vier Jahren Mukoviszidose feststellten, gaben sie meinen Eltern zu verstehen, dass ich wohl nicht erwachsen werden würde.“ Es kam zum Glück anders.
„Ich werde niemals aufgeben!“
Mit großer Disziplin, Medikamenten und der Teilnahme an Mukoviszidose-Forschungsprojekten gelang ihm das Wunder, und er lebt heute sogar nahezu beschwerdefrei. Seinen Kampf gegen die seltene Krankheit hat er deshalb ausgeweitet. „Noch immer ersticken viele Patienten an der Krankheit, bevor ihr Leben richtig beginnt. Passende Spenderlungen sind sehr rar, und auch Transplantation bergen viele Risiken. Am besten wäre es daher, wenn es gar nicht so weit kommen müsste“, erklärt Reiner Heske. „Darum möchte ich die Forschung unterstützen, wie und wo ich nur kann. Erst recht, wenn es so viel Spaß macht wie bei den Muko-Bike-Touren in Bocholt.“
Ein neu zugelassenes Medikament gibt Menschen mit Mukoviszidose Hoffnung auf mehr Lebensqualität.
Rund 8000 Menschen leben in Deutschland mit Mukoviszidose, einer angeborenen Stoffwechselerkrankung, bei der Schleim nicht richtig abfließen kann und lebenswichtige Organe verstopft. Neue Hoffnung für Patienten soll aktuell aus den USA kommen.
Die Förderungsgesellschaft hat seit 1986 die CF Forschergruppe an der MedHo Hannover unterstützt bei Forschungsvorhaben zu
1986 - heute
Diagnostik, Infektionskontrolle und Therapie der CF Atemwegsinfektionen mit Pseudomonaskeimen
1986 - 2010
Genetik der Mukoviszidose
1990 - heute
CFTR Forschung
1995 - 2002
Europäische CF Zwillingsstudie
1996 - 2005
Erweiterte CF Diagnostik mit Elektrophysiologie und Proteinchemie (NPD, ICM, CFTR Immunoblot)
2005 - heute
Studien an CFTR Modulatoren
Die Forschungsergebnisse wurden 1987 bis heute in 250 Publikationen zu Grundlagen, Infektiologie, Diagnostik und Therapie der Mukoviszidose veröffentlicht.
